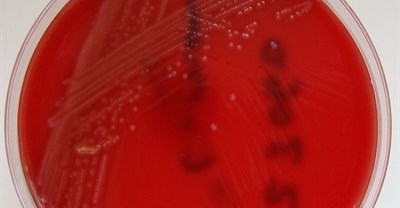

| |
| South Africa has had the biggest listeriosis outbreak in the world that resulted in more than 180 deaths to date... |
---|
|
|
---|
|
Marketing & Media |
 | LEIGH ANDREWS |
 | ANDY WALKER |
 | ROMI ADLER |
 | SHAE LEIGH |
 | |
 | |
|
Retail |
 | LAUREN HARTZENBERG |
|
Agriculture |
 | |
 | BEN COUSINS |
|
Automotive |
 | |
 | HENRIE GEYSER |
|
Construction & Engineering |
 | |
 | |
|
Education |
 | |
 | |
 | |
 | RAFFI DUYMEDJIAN AND ISABELLE NÉ |
|
Energy & Mining |
 | |
|
ESG & Sustainability |
 | |
 | THETO MAHLAKOANA |
|
Finance |
 | DANETTE BREITENBACH |
 | RENÉ GROBLER |
|
Healthcare |
 | |
|
Legal |
 | |
|
Lifestyle |
 | MARTIN MYERS |
|
Logistics & Transport |
 | MARCUS MAYERS, DAVID BAMFORD |
 | DOMINIC PREUSS |
|
Property |
 | ROB ROSE |
 | |
|
Tourism, Travel & Hospitality |
 | |
 | ISSUED BY WORLD TRAVEL MARKET AFRICA |
|
ICT |
 | |
 | NICK HEDLEY |
|
Featured Press Office of the day | More | Join |
|
|
 | Launched in the heart of Johannesburg in 1971. AdCheck provides a comprehensive advertising monitoring and analysis service to the Media & Advertising agencies, as well as Brand Owners. Assisting clients to enhance their own marketing & advertising strategies. |
Jobs offered |
|
|
|
|
|
|